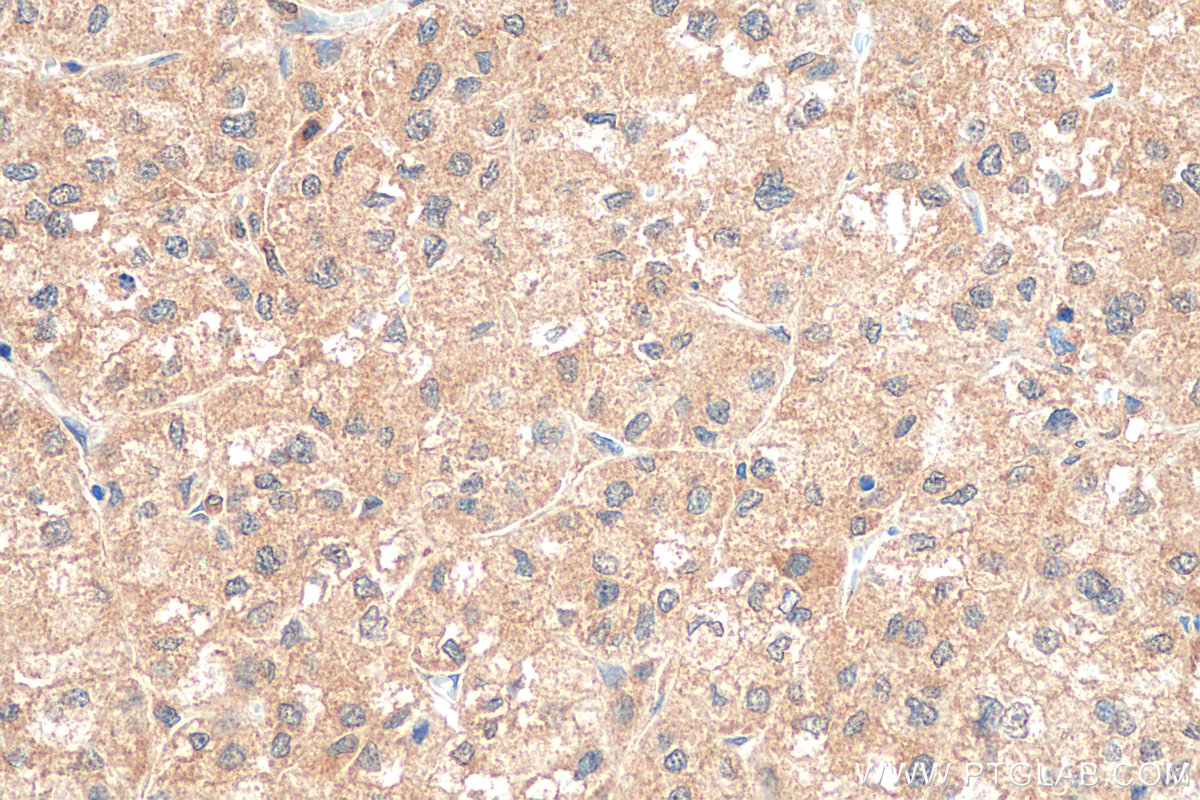

验证数据展示
经过测试的应用
| Positive WB detected in | A431 cells, COLO 320 cells, Jurkat cells, MCF-7 cells |
| Positive IP detected in | A431 cells |
| Positive IHC detected in | human liver cancer tissue Note: suggested antigen retrieval with TE buffer pH 9.0; (*) Alternatively, antigen retrieval may be performed with citrate buffer pH 6.0 |
| Positive IF/ICC detected in | HUVEC cells, NIH/3T3 cells, HepG2 cells |
推荐稀释比
| 应用 | 推荐稀释比 |
|---|---|
| Western Blot (WB) | WB : 1:2000-1:16000 |
| Immunoprecipitation (IP) | IP : 0.5-4.0 ug for 1.0-3.0 mg of total protein lysate |
| Immunohistochemistry (IHC) | IHC : 1:50-1:500 |
| Immunofluorescence (IF)/ICC | IF/ICC : 1:50-1:500 |
| It is recommended that this reagent should be titrated in each testing system to obtain optimal results. | |
| Sample-dependent, Check data in validation data gallery. | |
产品信息
10029-1-Ig targets Paxillin in WB, IHC, IF/ICC, IP, ELISA applications and shows reactivity with human, mouse samples.
| 经测试应用 | WB, IHC, IF/ICC, IP, ELISA Application Description |
| 文献引用应用 | WB, IHC, IF |
| 经测试反应性 | human, mouse |
| 文献引用反应性 | human, mouse, rat |
| 免疫原 |
Peptide 种属同源性预测 |
| 宿主/亚型 | Rabbit / IgG |
| 抗体类别 | Polyclonal |
| 产品类型 | Antibody |
| 全称 | paxillin |
| 别名 | PXN |
| 计算分子量 | 68 kDa |
| 观测分子量 | 68 kDa |
| GenBank蛋白编号 | NM_002859 |
| 基因名称 | Paxillin |
| Gene ID (NCBI) | 5829 |
| RRID | AB_513929 |
| 偶联类型 | Unconjugated |
| 形式 | Liquid |
| 纯化方式 | Protein A purification |
| UNIPROT ID | P49023 |
| 储存缓冲液 | PBS with 0.02% sodium azide and 50% glycerol, pH 7.3. |
| 储存条件 | Store at -20°C. Stable for one year after shipment. Aliquoting is unnecessary for -20oC storage. |
背景介绍
PXN (paxillin) is a 68 kDa scaffold protein that interacts with multiple structural and signaling proteins and regulates cell adhesion, migration, proliferation, and apoptosis. PXN is thought to play an important role in tumor migration, invasion, and metastasis (21045234). PXN has been identified as a direct substrate of protein tyrosine phosphatase receptor-type T (PTPRT), a potent tumor suppressor gene. Increased phospho-PXN at tyrosine residue 88 (Y88) has been found as a common feature of human colon cancers (20133777).
实验方案
| Product Specific Protocols | |
|---|---|
| IF protocol for Paxillin antibody 10029-1-Ig | Download protocol |
| IHC protocol for Paxillin antibody 10029-1-Ig | Download protocol |
| IP protocol for Paxillin antibody 10029-1-Ig | Download protocol |
| WB protocol for Paxillin antibody 10029-1-Ig | Download protocol |
| Standard Protocols | |
|---|---|
| Click here to view our Standard Protocols |
发表文章
| Species | Application | Title |
|---|---|---|
Mol Cell Direct epitranscriptomic regulation of mammalian translation initiation through N4-acetylcytidine. | ||
Sci Adv Bioactive fiber-reinforced hydrogel to tailor cell microenvironment for structural and functional regeneration of myotendinous junction | ||
Bone Res Impairment of rigidity sensing caused by mutant TP53 gain of function in osteosarcoma | ||
Cell Rep Mechanotransduction in response to ECM stiffening impairs cGAS immune signaling in tumor cells | ||
Cell Death Dis ZC3H15 promotes glioblastoma progression through regulating EGFR stability. |